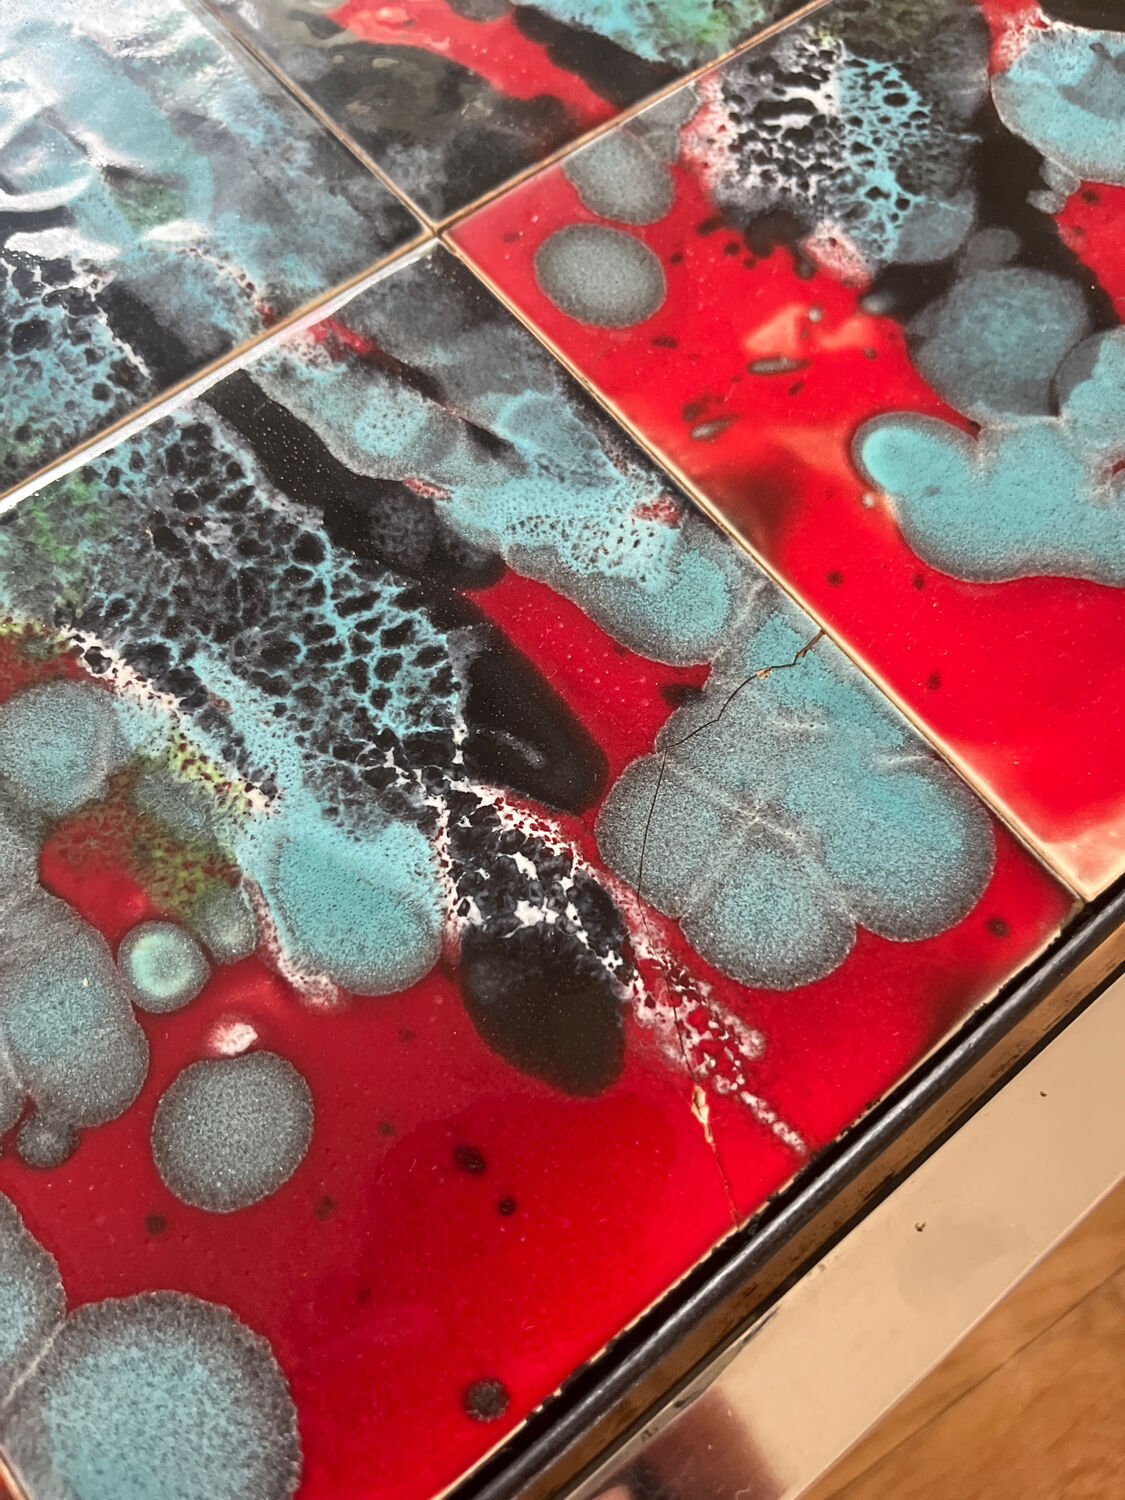
Earthenware table

Page 1 of 9
Earthenware table
€620 €720

Earthenware table
€620 €720
- Designer :
- Belarti
- Dimensions :
- H39 x W51 x D100
- Color :
- turquoise
- Material :
- ceramics, porcelain and earthenware
- Style :
- mid-century
Superb coffee table produced by Belarti (Belgium) in the 1970s. The top is made of enamelled ceramic tiles with abstract patterns in bright red, turquoise, black, and silver tones. Each tile features a very organic, almost volcanic enamel work, typical of Belgian artistic productions of the time. Minimalist chrome metal structure that perfectly highlights the graphic top. Model measures 100 x 50 cm, an ideal size for a living room or gallery space. Belarti signature visible. In very good vintage condition. Stable structure. Some slight signs of wear consistent with its age. A statement piece, perfect for a mid-century, brutalist, or contemporary interior.